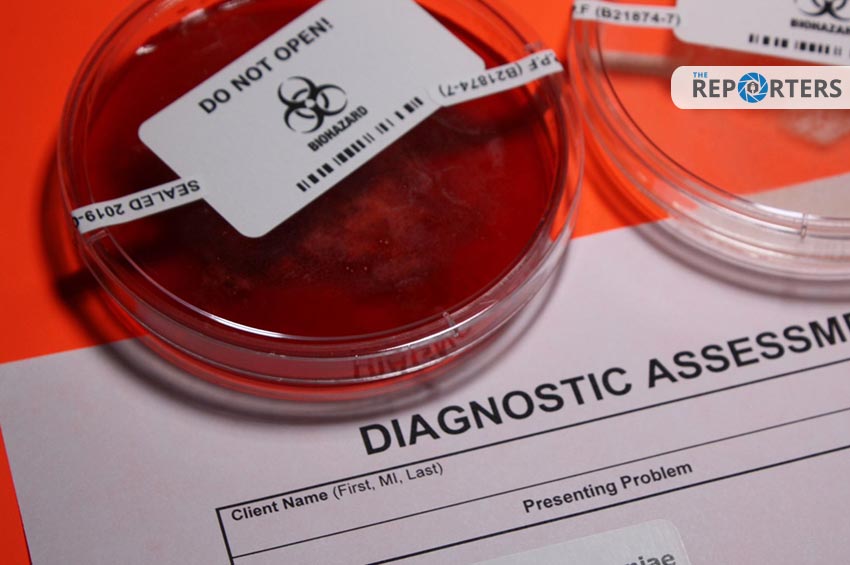

กรมควบคุมโรค แจงกรณีการเพิ่มขึ้นของโรคแบคทีเรียกินเนื้อในญี่ปุ่น
คาดส่วนหนึ่งมาจากการผ่อนคลายมาตรการป้องกันโควิด-19 ชี้รักษาได้หากพบแพทย์โดยเร็ว แนะรักษาสุขอนามัย-สวมหน้ากากอนามัยป้องกัน
กรมควบคุมโรค ชี้แจงถึงกรณีที่มีข่าวการเพิ่มขึ้นของโรคแบคทีเรียกินเนื้อที่เกิดจากการติดเชื้อแบคทีเรีย “สเตรปโตคอคคัส ชนิดเอ” ในประเทศญี่ปุ่น ที่ทางการญี่ปุ่นกำลังสืบค้นหาสาเหตุของการเพิ่มขึ้นว่า เชื้อดังกล่าวเป็นเชื้อก่อโรคที่มีมานานแล้ว และมีมากกว่า 200 สายพันธุ์ ก่อให้เกิดอาการหลายรูปแบบ ตั้งแต่การติดเชื้อของคอหอย ต่อมทอนซิล และระบบทางเดินหายใจ หรืออาจก่อให้เกิดการติดเชื้อที่ผิวหนังและเนื้อเยื่อชั้นใต้ผิวหนัง ส่วนหนึ่งของผู้ป่วยอาจมีอาการรุนแรง (ซึ่งพบเป็นส่วนน้อย) ได้แก่ มีการอักเสบอย่างรุนแรงของผิวหนังชั้นลึก หรือเกิดภาวะช็อกที่อาจมีอาการรุนแรงถึงขั้นเสียชีวิตได้
หนึ่งในอาการแสดงของโรคและอยู่ในระบบเฝ้าระวังของประเทศไทยคือ โรคไข้อีดำอีแดง (Scarlet fever) ซึ่งเป็นโรคติดต่อที่ต้องเฝ้าระวังตาม พ.ร.บ.โรคติดต่อ พ.ศ.2558 เกิดได้ทุกช่วงอายุแต่มักเป็นในเด็กวัยเรียน ติดต่อจากคนสู่คนโดยการใกล้ชิดและหายใจรับละอองฝอยของเสมหะ น้ำมูก น้ำลาย ที่มีเชื้อ หรือละอองเชื้อโรคสัมผัสกับตา จมูก ปาก หรือสัมผัสผ่านมือ สิ่งของเครื่องใช้ เช่น จาน ชาม แก้วน้ำ เป็นต้น อาการที่พบ คือ เจ็บคอ ปวดศีรษะ ไข้ และอาจมีผื่นนูนสาก ๆ ตามร่างกาย (จากเชื้อสร้างสารพิษ) สัมผัสแล้ว มีลักษณะคล้ายกระดาษทราย
กลุ่มเสี่ยงของโรคไข้อีดำอีแดงจะเป็นเด็กวัยเรียน อายุ 5-15 ปี ที่อยู่รวมกันจำนวนมาก จากข้อมูลการเฝ้าระวังโรคของกองระบาดวิทยา กรมควบคุมโรค ตั้งแต่ปี พ.ศ.2562 ถึงวันที่ 16 มีนาคม พ.ศ.2567 พบผู้ป่วย 4,989 ราย ไม่พบรายงานผู้เสียชีวิต สำหรับปี พ.ศ.2567 ยังไม่พบรายงาน
กรณีอาการรุนแรง จากระบบโครงสร้างฐานข้อมูลด้านการแพทย์และสุขภาพ (43 แฟ้ม) ของประเทศไทย ตั้งแต่ปี 2562-2566 กรณี Toxic Shock Syndrome พบว่ามีผู้ป่วยเข้ารับการรักษาเป็นผู้ป่วยในโรงพยาบาล 204 ราย เฉลี่ยปีละ 41 ราย และมีแนวโน้มลดต่ำลงในช่วงการแพร่ระบาดของโควิด 19 โดยปี 2566 พบผู้ป่วย 29 ราย
สำหรับกรณีโรคแบคทีเรียกินเนื้อหรือโรคเนื้อเน่า (Necrotizing fasciitis) อาจเกิดจากแบคทีเรียหลายชนิด (โดย 1 ในเชื้อสาเหตุคือ “สเตรปโตคอคคัส ชนิดเอ”) จากการติดตามใน 2562-2566 มีผู้ป่วยเข้ารับการรักษาในโรงพยาบาลทั้งสิ้น 106,021 ราย มีผู้เสียชีวิตด้วยภาวะดังกล่าว 1,048 ราย คิดเป็นอัตราป่วยตายประมาณร้อยละ 1.0 แนวโน้มการรายงานผู้ป่วยคงที่และลดลงในปี พ.ศ.2566 โดยมีอัตราป่วย 27.35 ต่อแสนประชากร (จากเดิมร้อยละ 32.5 ต่อแสนประชากร) พบรายงานผู้ป่วยตลอดทั้งปีแต่สูงสุดในเดือนมิถุนายน-กรกฎาคมของทุกปี
จากการติดตามข้อมูลดังกล่าว ยังไม่พบว่าอุบัติการณ์การติดเชื้อนี้มีการเพิ่มขึ้น หรือรุนแรงขึ้นในประเทศไทย การติดเชื้อนี้สามารถรักษาได้ด้วยยาปฏิชีวนะ ดังนั้น การพบแพทย์เพื่อรับการวินิจฉัยและรักษาแต่เนิ่น ๆ การได้รับยาปฏิชีวนะที่ถูกต้อง รวดเร็ว เหมาะสม จะช่วยลดความรุนแรงของโรค และช่วยลดการแพร่เชื้อสู่คนรอบข้างได้ ในรายที่อาการเป็นมากอาจต้องผ่าตัดเนื้อตายออก กลุ่มเสี่ยงที่อาจจะมีอาการรุนแรง คือ ผู้สูงอายุ ผู้ป่วยเบาหวาน ผู้ที่มีโรคประจำตัวหรือเป็นผู้ที่มีรอยโรคที่ผิวหนังมาก่อน
ทั้งนี้ การแพร่ระบาดหลักของเชื้อนี้เป็นทางระบบทางเดินหายใจ (โดยอาจร่วมกับการสัมผัสกับสิ่งคัดหลั่งหรือหนองจากแผล ในกรณีมีการติดเชื้อที่ผิวหนัง) และการติดเชื้อนี้พบได้ทุกช่วงอายุ ดังนั้น มาตรการการป้องกันการแพร่ระบาดของโควิด 19 จึงช่วยลดการแพร่ระบาดของเชื้อนี้เช่นกัน ประกอบกับการสวมหน้ากากอนามัย การล้างมือบ่อย ๆ การรักษาสุขอนามัยส่วนบุคคล ยังคงเป็นสิ่งจำเป็น โดยเฉพาะในสถานที่ที่มีคนอยู่รวมกันจำนวนมาก หรือเมื่อต้องเดินทางไปต่างประเทศ โดยเฉพาะในกลุ่มเสี่ยงควรต้องระมัดระวัง และรักษาสุขอนามัยส่วนบุคคลอย่างเคร่งครัด
อย่างไรก็ตาม กรมควบคุมโรคยังคงติดตามสถานการณ์โรคติดเชื้อสเตรปโตคอคคัส ชนิดเอ ในญี่ปุ่นอย่างต่อเนื่อง ขอประชาชนอย่าตื่นตระหนก แนะนำประชาชนถ้ามีไข้ เจ็บคอ ร่วมกับมีผื่นสากนูน หรือตุ่มหนองที่ผิวหนัง หรือปวดเมื่อยกล้ามเนื้อมาก ควรรีบไปพบแพทย์ โดยเฉพาะหลังกลับจากต่างประเทศ ภายใน 1 สัปดาห์แรก เพื่อรับการวินิจฉัย รักษา และแยกโรคอย่างถูกต้อง
















